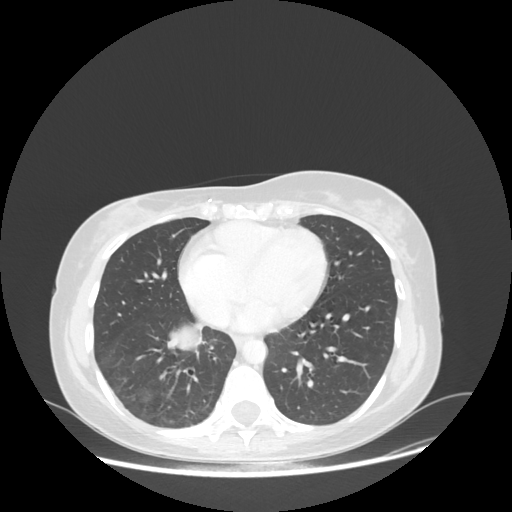
Original VENOUS CT scan

GAN Medical CT Evaluation Report
Patient: BMG07082017
Slice 70 Targeting Evaluation
Patient Information
Patient ID: BMG07082017
Model: cytran
Slice: Slice_70
Slice Thickness: 2.5mm
Conversion: NATIVE → VENOUS
📊 Download Metrics
📥 Download CSV Metrics (patient_BMG07082017_metrics.csv)Contains all 4 metric datasets: Network-Normalized, Hounsfield Units, Lung Window, and Mediastinum Window
Native→Venous Translation Metrics (Generated Venous vs Real Venous)
Targeted Slice 70 - Network-Normalized Analysis (Generated vs Real Venous)
0.840
SSIM Score
0.131
RMSE
0.057
MAE
Average Network-Normalized Metrics Across All Slices (103 slices) - Generated vs Real Venous
0.848
SSIM Score (Avg)
0.127
RMSE (Avg)
0.054
MAE (Avg)
Targeted Slice 70 - HU-Space Analysis (Generated vs Real Venous)
0.840
HU SSIM
131.0
HU RMSE
56.9
HU MAE
Average HU-Space Metrics Across All Slices (103 slices) - Generated vs Real Venous
0.848
HU SSIM (Avg)
127.5
HU RMSE (Avg)
54.4
HU MAE (Avg)
Targeted Slice 70 - Lung Window Analysis (Generated vs Real Venous)
0.720
Lung SSIM
114.8
Lung RMSE
45.1
Lung MAE
Average Lung Window Metrics Across All Slices (103 slices) - Generated vs Real Venous
0.735
Lung SSIM (Avg)
109.1
Lung RMSE (Avg)
41.9
Lung MAE (Avg)
Targeted Slice 70 - Mediastinum Window Analysis (Generated vs Real Venous)
0.784
Mediastinum SSIM
43.0
Mediastinum RMSE
13.8
Mediastinum MAE
Average Mediastinum Window Metrics Across All Slices (103 slices) - Generated vs Real Venous
0.762
Mediastinum SSIM (Avg)
44.5
Mediastinum RMSE (Avg)
15.0
Mediastinum MAE (Avg)
Detailed Per-Slice Metrics
| Slice ID | SSIM | RMSE | MAE | HU SSIM | HU RMSE | HU MAE | Lung SSIM | Lung RMSE | Lung MAE | Mediastinum SSIM | Mediastinum RMSE | Mediastinum MAE |
|---|---|---|---|---|---|---|---|---|---|---|---|---|
| BMG07082017_slice_0 | 0.877 | 0.099 | 0.044 | 0.877 | 98.6 | 44.0 | 0.781 | 72.2 | 29.7 | 0.721 | 40.9 | 16.2 |
| BMG07082017_slice_1 | 0.877 | 0.099 | 0.044 | 0.877 | 98.9 | 44.0 | 0.782 | 72.3 | 29.4 | 0.721 | 40.6 | 16.0 |
| BMG07082017_slice_2 | 0.874 | 0.103 | 0.045 | 0.874 | 102.6 | 45.2 | 0.782 | 74.9 | 30.1 | 0.723 | 41.3 | 16.0 |
| BMG07082017_slice_3 | 0.872 | 0.109 | 0.047 | 0.872 | 108.8 | 46.6 | 0.779 | 79.7 | 31.2 | 0.723 | 41.7 | 15.9 |
| BMG07082017_slice_4 | 0.870 | 0.113 | 0.048 | 0.870 | 113.2 | 47.7 | 0.777 | 83.5 | 31.9 | 0.723 | 42.1 | 15.9 |
| BMG07082017_slice_5 | 0.864 | 0.115 | 0.049 | 0.864 | 115.1 | 48.6 | 0.769 | 86.0 | 32.9 | 0.724 | 43.9 | 16.5 |
| BMG07082017_slice_6 | 0.864 | 0.115 | 0.049 | 0.864 | 114.8 | 48.5 | 0.768 | 87.7 | 33.4 | 0.727 | 42.5 | 16.1 |
| BMG07082017_slice_7 | 0.861 | 0.115 | 0.049 | 0.861 | 115.4 | 49.1 | 0.764 | 89.2 | 34.2 | 0.728 | 42.3 | 16.2 |
| BMG07082017_slice_8 | 0.861 | 0.118 | 0.049 | 0.861 | 117.5 | 49.5 | 0.763 | 91.5 | 34.8 | 0.732 | 42.7 | 16.2 |
| BMG07082017_slice_9 | 0.859 | 0.122 | 0.050 | 0.859 | 122.4 | 50.1 | 0.763 | 92.4 | 35.0 | 0.737 | 43.5 | 16.1 |
| BMG07082017_slice_10 | 0.856 | 0.125 | 0.051 | 0.856 | 125.3 | 51.1 | 0.758 | 93.9 | 35.6 | 0.742 | 45.2 | 16.5 |
| BMG07082017_slice_11 | 0.856 | 0.126 | 0.051 | 0.856 | 125.9 | 51.4 | 0.756 | 94.9 | 35.8 | 0.742 | 45.4 | 16.4 |
| BMG07082017_slice_12 | 0.860 | 0.126 | 0.051 | 0.860 | 125.7 | 51.3 | 0.762 | 95.6 | 35.5 | 0.748 | 45.3 | 16.0 |
| BMG07082017_slice_13 | 0.859 | 0.125 | 0.051 | 0.859 | 125.3 | 51.3 | 0.764 | 96.3 | 35.6 | 0.750 | 44.9 | 15.7 |
| BMG07082017_slice_14 | 0.858 | 0.124 | 0.051 | 0.858 | 124.3 | 51.1 | 0.765 | 97.1 | 35.7 | 0.753 | 44.5 | 15.5 |
| BMG07082017_slice_15 | 0.856 | 0.125 | 0.052 | 0.856 | 125.1 | 51.6 | 0.763 | 97.9 | 36.1 | 0.757 | 45.9 | 15.6 |
| BMG07082017_slice_16 | 0.857 | 0.126 | 0.052 | 0.857 | 125.6 | 51.9 | 0.763 | 99.0 | 36.6 | 0.760 | 47.0 | 15.7 |
| BMG07082017_slice_17 | 0.857 | 0.125 | 0.052 | 0.857 | 125.3 | 51.9 | 0.763 | 99.7 | 36.7 | 0.764 | 47.1 | 15.7 |
| BMG07082017_slice_18 | 0.858 | 0.124 | 0.051 | 0.858 | 123.7 | 51.4 | 0.762 | 100.1 | 36.8 | 0.768 | 45.7 | 15.2 |
| BMG07082017_slice_19 | 0.856 | 0.123 | 0.051 | 0.856 | 122.7 | 51.5 | 0.758 | 101.1 | 37.3 | 0.769 | 44.9 | 14.9 |
| BMG07082017_slice_20 | 0.855 | 0.123 | 0.052 | 0.855 | 123.1 | 51.7 | 0.755 | 101.8 | 37.7 | 0.770 | 44.7 | 14.8 |
| BMG07082017_slice_21 | 0.853 | 0.124 | 0.052 | 0.853 | 124.3 | 52.3 | 0.753 | 103.9 | 38.5 | 0.770 | 44.9 | 14.8 |
| BMG07082017_slice_22 | 0.854 | 0.124 | 0.052 | 0.854 | 124.3 | 52.2 | 0.753 | 104.9 | 38.9 | 0.772 | 44.0 | 14.5 |
| BMG07082017_slice_23 | 0.852 | 0.125 | 0.052 | 0.852 | 125.3 | 52.4 | 0.750 | 106.2 | 39.6 | 0.773 | 43.9 | 14.4 |
| BMG07082017_slice_24 | 0.850 | 0.126 | 0.053 | 0.850 | 126.4 | 53.0 | 0.746 | 108.6 | 40.6 | 0.774 | 43.9 | 14.5 |
| BMG07082017_slice_25 | 0.849 | 0.127 | 0.053 | 0.849 | 127.2 | 53.2 | 0.742 | 109.5 | 40.9 | 0.776 | 44.0 | 14.3 |
| BMG07082017_slice_26 | 0.845 | 0.131 | 0.055 | 0.845 | 131.1 | 54.9 | 0.735 | 112.6 | 42.1 | 0.774 | 45.1 | 14.6 |
| BMG07082017_slice_27 | 0.843 | 0.134 | 0.056 | 0.843 | 133.9 | 56.0 | 0.732 | 114.4 | 42.9 | 0.775 | 45.4 | 14.6 |
| BMG07082017_slice_28 | 0.844 | 0.134 | 0.056 | 0.844 | 134.1 | 56.0 | 0.731 | 114.3 | 42.9 | 0.778 | 45.6 | 14.5 |
| BMG07082017_slice_29 | 0.844 | 0.133 | 0.056 | 0.844 | 133.1 | 56.1 | 0.731 | 113.3 | 42.9 | 0.779 | 45.2 | 14.4 |
| BMG07082017_slice_30 | 0.845 | 0.131 | 0.055 | 0.845 | 130.6 | 55.2 | 0.731 | 111.4 | 42.3 | 0.781 | 44.9 | 14.3 |
| BMG07082017_slice_31 | 0.848 | 0.127 | 0.054 | 0.848 | 127.3 | 54.2 | 0.735 | 109.9 | 42.0 | 0.784 | 44.4 | 14.1 |
| BMG07082017_slice_32 | 0.846 | 0.127 | 0.054 | 0.846 | 126.8 | 54.2 | 0.733 | 110.5 | 42.6 | 0.784 | 43.9 | 14.0 |
| BMG07082017_slice_33 | 0.847 | 0.127 | 0.054 | 0.847 | 127.0 | 54.2 | 0.733 | 111.7 | 42.9 | 0.786 | 43.2 | 13.9 |
| BMG07082017_slice_34 | 0.848 | 0.125 | 0.054 | 0.848 | 125.4 | 53.9 | 0.731 | 110.2 | 42.5 | 0.788 | 43.5 | 13.9 |
| BMG07082017_slice_35 | 0.845 | 0.127 | 0.055 | 0.845 | 127.1 | 55.0 | 0.727 | 110.9 | 42.9 | 0.789 | 43.9 | 14.0 |
| BMG07082017_slice_36 | 0.844 | 0.129 | 0.056 | 0.844 | 128.9 | 55.6 | 0.723 | 111.6 | 43.4 | 0.792 | 43.9 | 13.8 |
| BMG07082017_slice_37 | 0.843 | 0.131 | 0.056 | 0.843 | 130.6 | 56.1 | 0.722 | 111.6 | 43.4 | 0.790 | 44.4 | 14.1 |
| BMG07082017_slice_38 | 0.840 | 0.132 | 0.057 | 0.840 | 132.5 | 57.1 | 0.721 | 113.9 | 44.2 | 0.789 | 44.0 | 14.0 |
| BMG07082017_slice_39 | 0.834 | 0.135 | 0.058 | 0.834 | 134.6 | 58.5 | 0.717 | 117.4 | 45.9 | 0.785 | 44.6 | 14.3 |
| BMG07082017_slice_40 | 0.831 | 0.135 | 0.059 | 0.831 | 134.9 | 59.1 | 0.714 | 119.4 | 47.0 | 0.783 | 44.4 | 14.4 |
| BMG07082017_slice_41 | 0.829 | 0.133 | 0.059 | 0.829 | 132.9 | 58.6 | 0.710 | 118.5 | 46.9 | 0.780 | 44.9 | 14.8 |
| BMG07082017_slice_42 | 0.826 | 0.136 | 0.059 | 0.826 | 135.8 | 59.1 | 0.706 | 122.1 | 47.8 | 0.777 | 45.1 | 14.9 |
| BMG07082017_slice_43 | 0.829 | 0.134 | 0.058 | 0.829 | 134.4 | 58.3 | 0.705 | 120.5 | 47.1 | 0.779 | 44.3 | 14.6 |
| BMG07082017_slice_44 | 0.827 | 0.135 | 0.059 | 0.827 | 134.6 | 58.9 | 0.702 | 120.1 | 47.6 | 0.777 | 46.8 | 15.4 |
| BMG07082017_slice_45 | 0.826 | 0.142 | 0.062 | 0.826 | 142.3 | 62.0 | 0.701 | 128.2 | 50.4 | 0.779 | 45.7 | 15.1 |
| BMG07082017_slice_46 | 0.828 | 0.137 | 0.060 | 0.828 | 136.9 | 59.7 | 0.703 | 120.6 | 47.7 | 0.782 | 46.2 | 14.9 |
| BMG07082017_slice_47 | 0.827 | 0.142 | 0.062 | 0.827 | 142.4 | 62.1 | 0.701 | 125.2 | 49.1 | 0.775 | 46.7 | 15.0 |
| BMG07082017_slice_48 | 0.825 | 0.143 | 0.062 | 0.825 | 143.2 | 62.4 | 0.699 | 124.4 | 49.2 | 0.777 | 48.0 | 15.2 |
| BMG07082017_slice_49 | 0.830 | 0.137 | 0.060 | 0.830 | 137.0 | 59.5 | 0.707 | 116.8 | 45.9 | 0.779 | 47.9 | 15.4 |
| BMG07082017_slice_50 | 0.835 | 0.132 | 0.058 | 0.835 | 132.1 | 58.0 | 0.713 | 113.9 | 45.0 | 0.781 | 47.0 | 15.2 |
| BMG07082017_slice_51 | 0.828 | 0.134 | 0.060 | 0.828 | 134.0 | 59.8 | 0.705 | 118.2 | 47.4 | 0.770 | 47.1 | 15.7 |
| BMG07082017_slice_52 | 0.830 | 0.135 | 0.060 | 0.830 | 134.6 | 60.3 | 0.701 | 120.2 | 48.4 | 0.780 | 45.2 | 14.6 |
| BMG07082017_slice_53 | 0.829 | 0.134 | 0.059 | 0.829 | 134.1 | 59.0 | 0.702 | 121.0 | 47.8 | 0.777 | 44.6 | 14.5 |
| BMG07082017_slice_54 | 0.830 | 0.134 | 0.059 | 0.830 | 134.2 | 58.6 | 0.701 | 121.1 | 47.7 | 0.774 | 44.9 | 14.6 |
| BMG07082017_slice_55 | 0.827 | 0.133 | 0.059 | 0.827 | 133.1 | 58.7 | 0.698 | 120.2 | 47.7 | 0.775 | 44.9 | 14.6 |
| BMG07082017_slice_56 | 0.827 | 0.135 | 0.059 | 0.827 | 135.3 | 59.4 | 0.701 | 121.9 | 48.0 | 0.777 | 44.8 | 14.5 |
| BMG07082017_slice_57 | 0.828 | 0.139 | 0.060 | 0.828 | 138.9 | 60.4 | 0.701 | 124.2 | 48.6 | 0.773 | 46.1 | 15.0 |
| BMG07082017_slice_58 | 0.821 | 0.144 | 0.062 | 0.821 | 143.8 | 62.1 | 0.696 | 128.1 | 49.8 | 0.770 | 47.8 | 15.7 |
| BMG07082017_slice_59 | 0.822 | 0.143 | 0.062 | 0.822 | 142.8 | 62.2 | 0.698 | 127.2 | 49.7 | 0.774 | 46.5 | 15.1 |
| BMG07082017_slice_60 | 0.820 | 0.141 | 0.062 | 0.820 | 141.4 | 61.9 | 0.695 | 125.1 | 49.4 | 0.774 | 46.6 | 15.3 |
| BMG07082017_slice_61 | 0.819 | 0.140 | 0.062 | 0.819 | 140.3 | 61.9 | 0.695 | 124.8 | 49.8 | 0.771 | 46.6 | 15.5 |
| BMG07082017_slice_62 | 0.820 | 0.138 | 0.061 | 0.820 | 138.5 | 61.2 | 0.698 | 123.3 | 49.3 | 0.774 | 46.0 | 15.4 |
| BMG07082017_slice_63 | 0.826 | 0.137 | 0.060 | 0.826 | 136.9 | 60.0 | 0.702 | 122.8 | 48.7 | 0.776 | 45.1 | 15.0 |
| BMG07082017_slice_64 | 0.828 | 0.137 | 0.059 | 0.828 | 136.8 | 59.3 | 0.705 | 123.1 | 48.3 | 0.776 | 44.2 | 14.6 |
| BMG07082017_slice_65 | 0.836 | 0.136 | 0.059 | 0.836 | 135.9 | 58.6 | 0.714 | 122.1 | 47.6 | 0.782 | 43.8 | 14.2 |
| BMG07082017_slice_66 | 0.839 | 0.136 | 0.058 | 0.839 | 135.7 | 58.3 | 0.717 | 121.4 | 47.0 | 0.784 | 43.6 | 14.0 |
| BMG07082017_slice_67 | 0.839 | 0.135 | 0.058 | 0.839 | 135.1 | 58.2 | 0.716 | 120.0 | 46.5 | 0.784 | 43.9 | 14.0 |
| BMG07082017_slice_68 | 0.837 | 0.135 | 0.058 | 0.837 | 135.2 | 58.3 | 0.715 | 118.7 | 46.4 | 0.785 | 44.4 | 14.1 |
| BMG07082017_slice_69 | 0.837 | 0.134 | 0.058 | 0.837 | 133.6 | 57.7 | 0.716 | 116.6 | 45.7 | 0.784 | 43.4 | 13.8 |
| BMG07082017_slice_70 | 0.840 | 0.131 | 0.057 | 0.840 | 131.0 | 56.9 | 0.720 | 114.8 | 45.1 | 0.784 | 43.0 | 13.8 |
| BMG07082017_slice_71 | 0.843 | 0.128 | 0.056 | 0.843 | 128.0 | 55.9 | 0.726 | 112.2 | 44.4 | 0.788 | 42.3 | 13.6 |
| BMG07082017_slice_72 | 0.841 | 0.128 | 0.056 | 0.841 | 127.6 | 56.4 | 0.724 | 112.4 | 44.9 | 0.784 | 42.2 | 13.6 |
| BMG07082017_slice_73 | 0.844 | 0.127 | 0.056 | 0.844 | 126.6 | 56.1 | 0.725 | 111.5 | 44.6 | 0.785 | 41.6 | 13.3 |
| BMG07082017_slice_74 | 0.843 | 0.125 | 0.056 | 0.843 | 125.4 | 56.0 | 0.724 | 110.5 | 44.6 | 0.787 | 41.8 | 13.4 |
| BMG07082017_slice_75 | 0.845 | 0.126 | 0.056 | 0.845 | 125.5 | 55.8 | 0.726 | 110.9 | 44.4 | 0.791 | 42.0 | 13.3 |
| BMG07082017_slice_76 | 0.840 | 0.129 | 0.058 | 0.840 | 128.8 | 58.0 | 0.721 | 114.4 | 46.5 | 0.793 | 42.6 | 13.6 |
| BMG07082017_slice_77 | 0.829 | 0.139 | 0.062 | 0.829 | 138.8 | 62.3 | 0.714 | 125.2 | 50.5 | 0.785 | 45.8 | 14.9 |
| BMG07082017_slice_78 | 0.830 | 0.137 | 0.062 | 0.830 | 137.5 | 61.6 | 0.716 | 122.9 | 49.5 | 0.786 | 46.9 | 15.4 |
| BMG07082017_slice_79 | 0.835 | 0.136 | 0.061 | 0.835 | 135.6 | 60.7 | 0.721 | 119.3 | 48.0 | 0.789 | 45.3 | 14.5 |
| BMG07082017_slice_80 | 0.829 | 0.141 | 0.064 | 0.829 | 141.3 | 64.2 | 0.718 | 124.4 | 50.6 | 0.779 | 45.7 | 15.1 |
| BMG07082017_slice_81 | 0.830 | 0.146 | 0.065 | 0.830 | 145.6 | 64.8 | 0.723 | 129.2 | 51.4 | 0.768 | 47.1 | 15.9 |
| BMG07082017_slice_82 | 0.838 | 0.145 | 0.062 | 0.838 | 145.0 | 62.4 | 0.733 | 129.6 | 50.0 | 0.762 | 47.4 | 15.9 |
| BMG07082017_slice_83 | 0.844 | 0.142 | 0.060 | 0.844 | 142.0 | 59.6 | 0.739 | 127.4 | 48.0 | 0.756 | 46.8 | 15.8 |
| BMG07082017_slice_84 | 0.847 | 0.138 | 0.057 | 0.847 | 138.3 | 57.1 | 0.743 | 124.6 | 46.3 | 0.750 | 46.4 | 16.0 |
| BMG07082017_slice_85 | 0.856 | 0.133 | 0.055 | 0.856 | 132.9 | 54.6 | 0.751 | 119.5 | 44.2 | 0.746 | 45.6 | 15.9 |
| BMG07082017_slice_86 | 0.860 | 0.130 | 0.053 | 0.860 | 130.3 | 52.8 | 0.754 | 116.6 | 42.7 | 0.739 | 45.5 | 15.8 |
| BMG07082017_slice_87 | 0.866 | 0.128 | 0.051 | 0.866 | 128.0 | 51.3 | 0.758 | 114.0 | 41.1 | 0.735 | 44.9 | 15.5 |
| BMG07082017_slice_88 | 0.869 | 0.125 | 0.050 | 0.869 | 124.6 | 50.1 | 0.760 | 110.6 | 39.8 | 0.730 | 44.6 | 15.5 |
| BMG07082017_slice_89 | 0.870 | 0.125 | 0.050 | 0.870 | 124.6 | 49.8 | 0.760 | 110.4 | 39.4 | 0.728 | 44.4 | 15.7 |
| BMG07082017_slice_90 | 0.872 | 0.125 | 0.049 | 0.872 | 124.9 | 49.4 | 0.761 | 110.7 | 38.9 | 0.722 | 44.3 | 15.7 |
| BMG07082017_slice_91 | 0.871 | 0.124 | 0.049 | 0.871 | 124.3 | 48.9 | 0.760 | 109.5 | 38.3 | 0.718 | 44.9 | 15.9 |
| BMG07082017_slice_92 | 0.872 | 0.121 | 0.048 | 0.872 | 120.8 | 47.9 | 0.760 | 104.7 | 36.9 | 0.716 | 44.9 | 16.1 |
| BMG07082017_slice_93 | 0.873 | 0.117 | 0.047 | 0.873 | 117.1 | 46.8 | 0.758 | 99.9 | 35.6 | 0.715 | 44.3 | 16.0 |
| BMG07082017_slice_94 | 0.876 | 0.114 | 0.046 | 0.876 | 113.9 | 45.6 | 0.761 | 95.7 | 34.2 | 0.717 | 42.7 | 15.5 |
| BMG07082017_slice_95 | 0.876 | 0.112 | 0.045 | 0.876 | 112.4 | 45.0 | 0.759 | 93.0 | 33.3 | 0.716 | 42.4 | 15.4 |
| BMG07082017_slice_96 | 0.878 | 0.109 | 0.044 | 0.878 | 109.1 | 43.7 | 0.763 | 88.5 | 32.0 | 0.719 | 42.4 | 15.3 |
| BMG07082017_slice_97 | 0.879 | 0.104 | 0.043 | 0.879 | 104.1 | 42.7 | 0.762 | 83.8 | 31.3 | 0.719 | 42.1 | 15.2 |
| BMG07082017_slice_98 | 0.879 | 0.101 | 0.042 | 0.879 | 101.0 | 42.0 | 0.762 | 82.0 | 31.0 | 0.720 | 41.5 | 15.2 |
| BMG07082017_slice_99 | 0.876 | 0.100 | 0.042 | 0.876 | 100.4 | 42.0 | 0.759 | 82.7 | 31.2 | 0.717 | 41.5 | 15.5 |
| BMG07082017_slice_100 | 0.875 | 0.101 | 0.042 | 0.875 | 101.4 | 42.1 | 0.757 | 84.4 | 31.6 | 0.717 | 41.5 | 15.6 |
| BMG07082017_slice_101 | 0.872 | 0.104 | 0.043 | 0.872 | 103.9 | 43.0 | 0.755 | 86.2 | 32.1 | 0.716 | 42.3 | 16.0 |
| BMG07082017_slice_102 | 0.869 | 0.106 | 0.044 | 0.869 | 105.6 | 43.5 | 0.753 | 88.0 | 32.6 | 0.717 | 42.5 | 16.1 |
Image Grid
4×3 grid: Rows show different image types (Original NATIVE, Reconstructed NATIVE, Original VENOUS, Generated VENOUS), Columns show windowing techniques (No Window, Lung Window, Mediastinum Window)
Original NATIVE CT scan (input)
No window - Raw intensity values

Original NATIVE CT scan (input)
Lung window (WL -600, WW 1500 → Low −1350, High +150)

Original NATIVE CT scan (input)
Mediastinum window (WL 40, WW 400 → Low −160, High +240)

Reconstructed NATIVE CT scan (cycle consistency)
No window - Raw intensity values

Reconstructed NATIVE CT scan (cycle consistency)
Lung window (WL -600, WW 1500 → Low −1350, High +150)

Reconstructed NATIVE CT scan (cycle consistency)
Mediastinum window (WL 40, WW 400 → Low −160, High +240)

Original VENOUS CT scan
No window - Raw intensity values

Original VENOUS CT scan
Lung window (WL -600, WW 1500 → Low −1350, High +150)
Original VENOUS CT scan
Mediastinum window (WL 40, WW 400 → Low −160, High +240)

Generated VENOUS CT scan (A→B translation)
No window - Raw intensity values

Generated VENOUS CT scan (A→B translation)
Lung window (WL -600, WW 1500 → Low −1350, High +150)

Generated VENOUS CT scan (A→B translation)
Mediastinum window (WL 40, WW 400 → Low −160, High +240)

Windowing Parameters
- No Window: Raw intensity values without windowing
- Lung Window: WL -600, WW 1500 → Low −1350, High +150 (optimal for pulmonary structures)
- Mediastinum Window: WL 40, WW 400 → Low −160, High +240 (optimal for soft tissues)